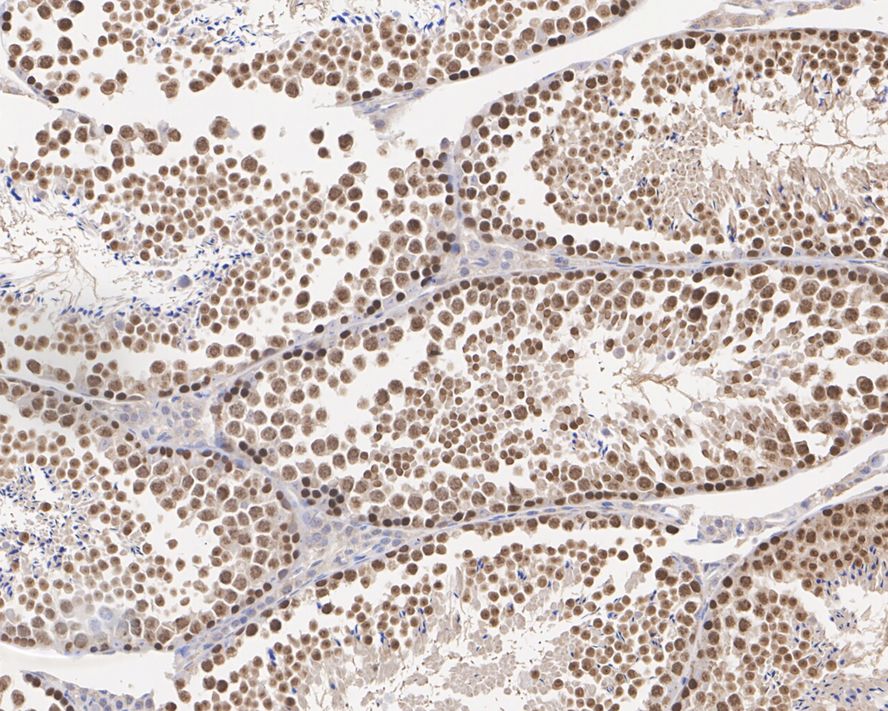

Catalog# HA500543
MNK2 Rabbit Polyclonal Antibody
Application
-
WB
-
IHC-P
Reactivity
-
Human
-
Mouse
-
Rat
Conjugation
-
unconjugated